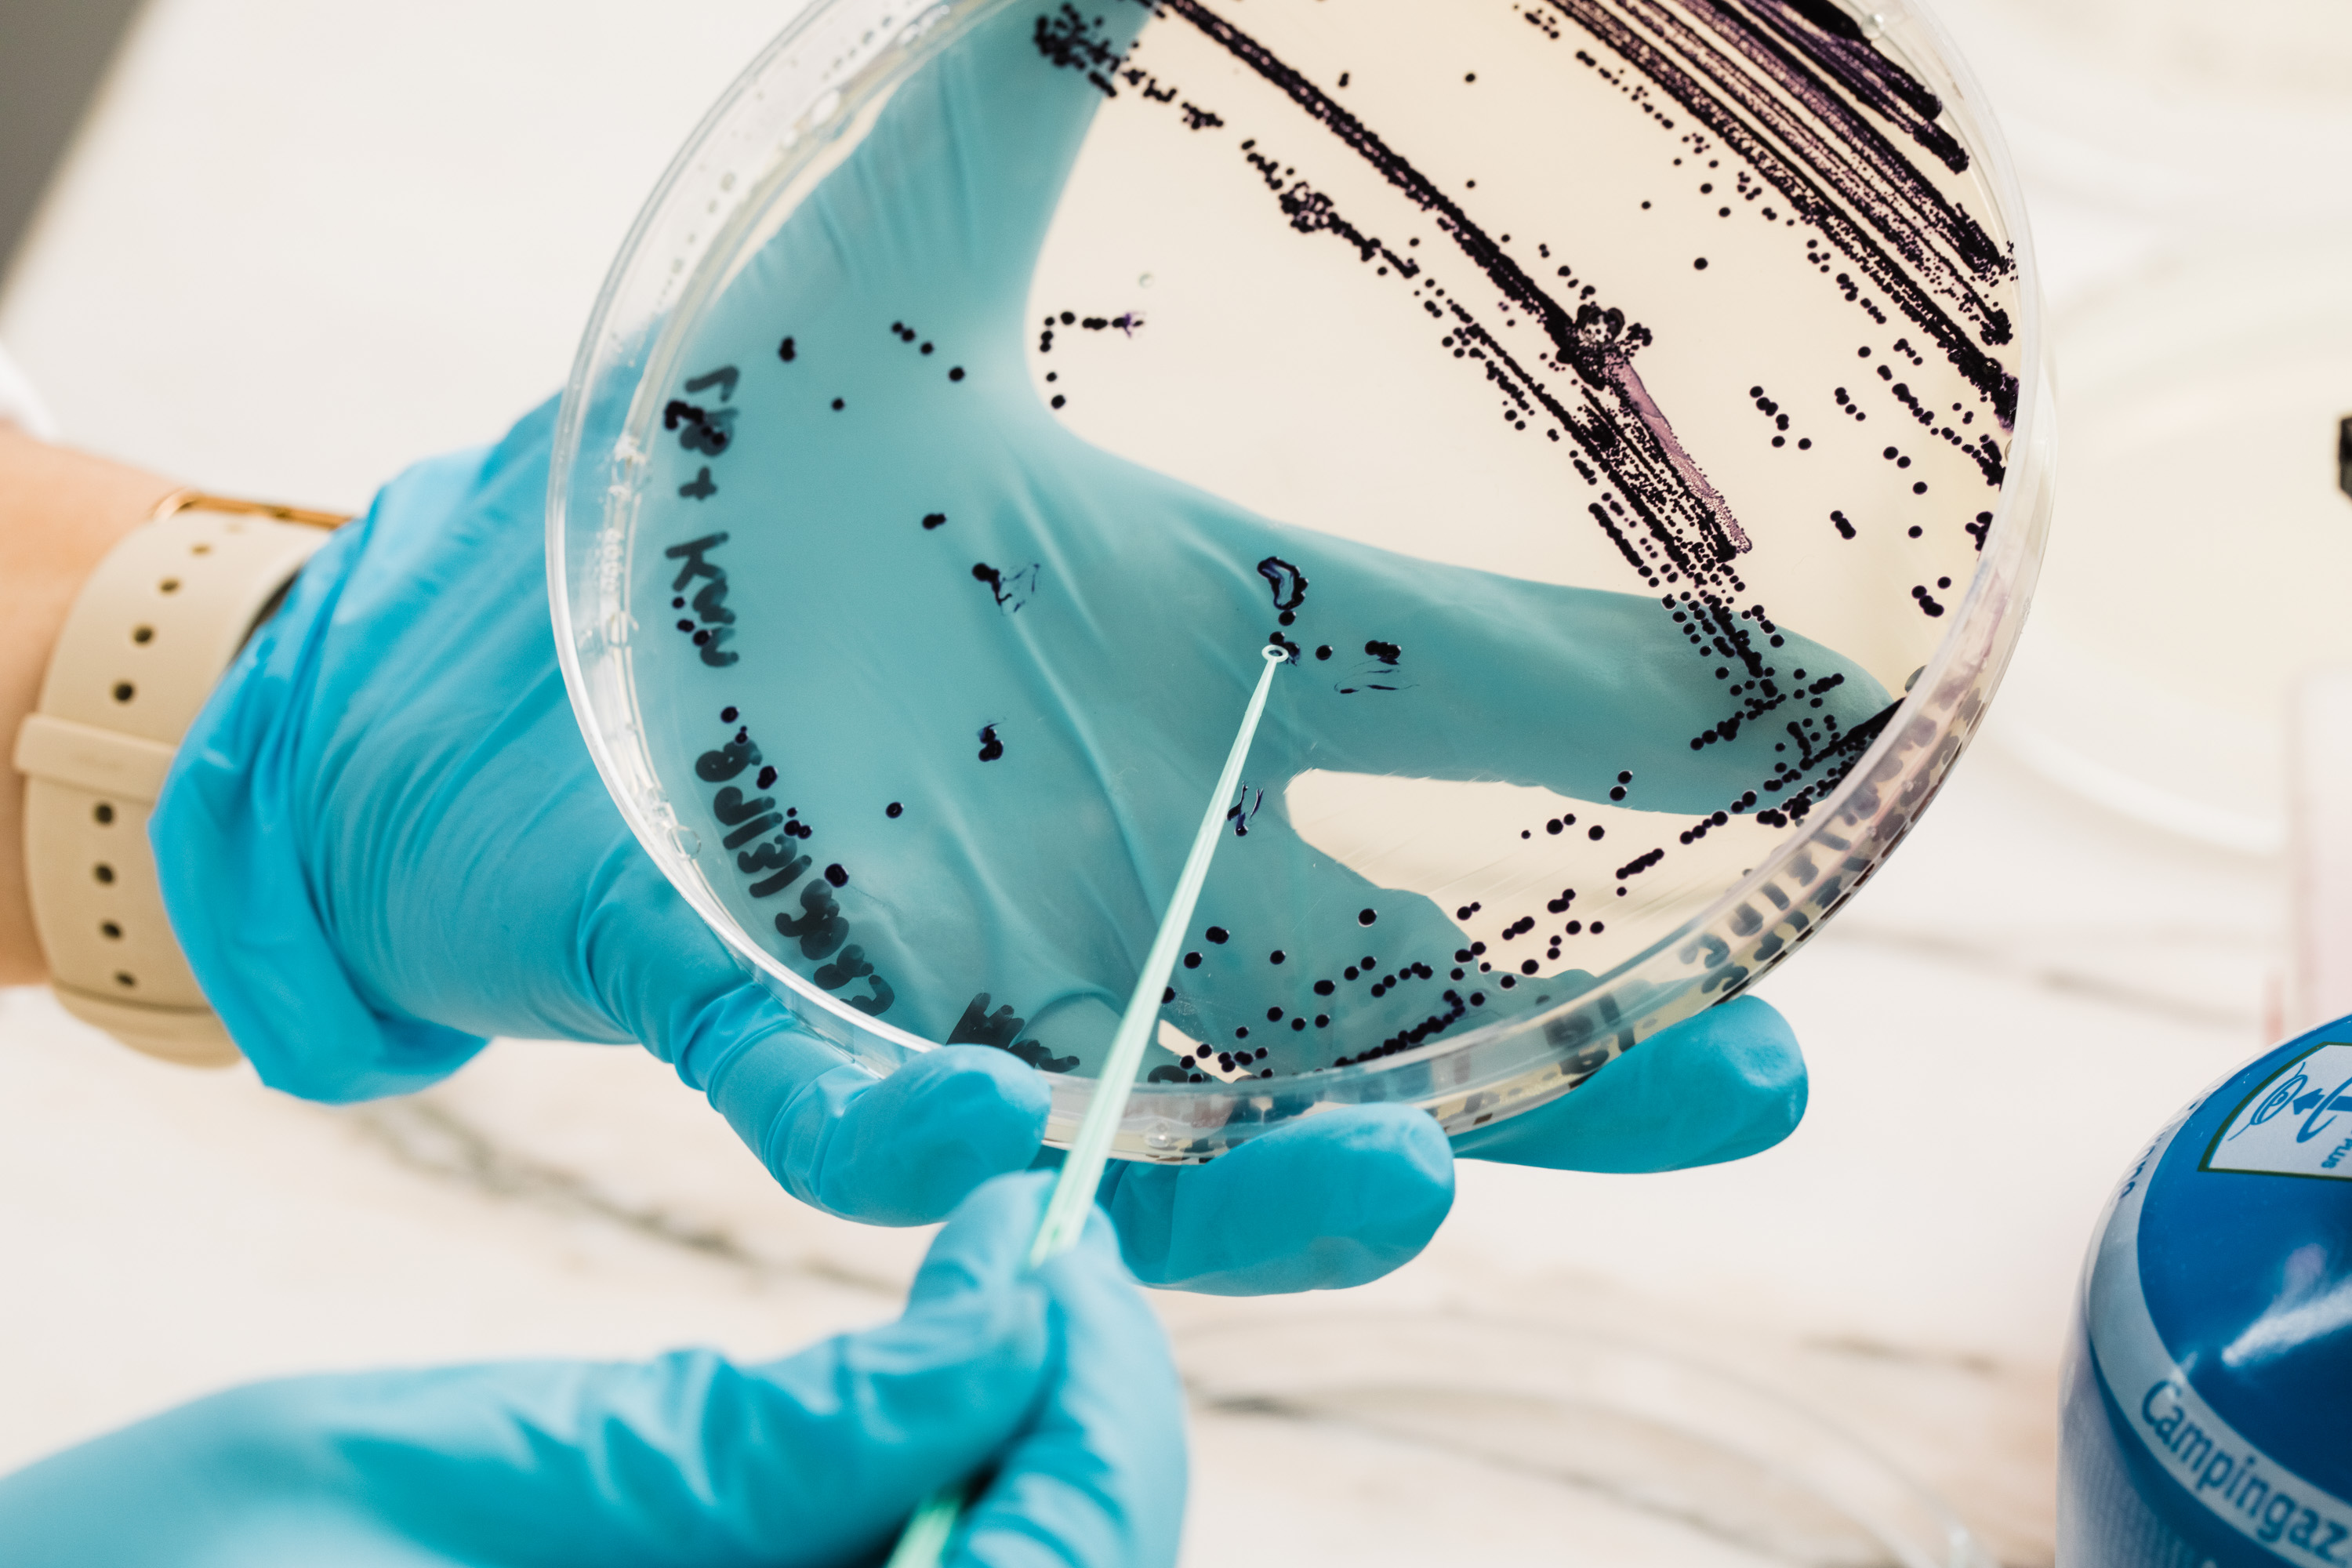

FROM LAB TO LIFE
RDD is a textile innovation company based in Portugal, rethinking how materials are imagined, made, and valued by bringing together science, design, and technology. Our work transforms research into tangible solutions that support a more responsible textile industry while respecting the planet and the people behind every process.
.mp4%202026-01-13%2011-38-47.jpg)
%20(1).jpg)


.jpg)